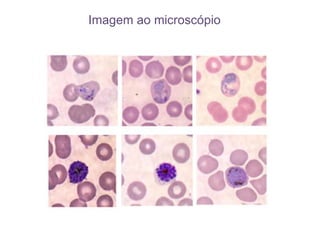
Imagem ao microscópio

O documento descreve os principais grupos do reino Protista, incluindo protozoários como amibas e paramécias, algas verdes, castanhas e vermelhas, e protistas semelhantes a fungos. Detalha as características, reprodução e importância destes organismos unicelulares e simples.